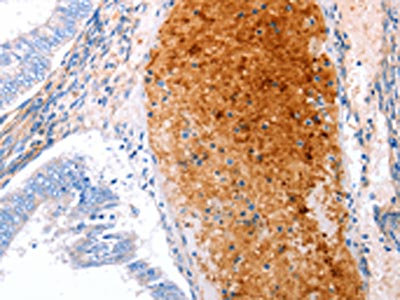

GRB10 Antibody
-
中文名稱:GRB10兔多克隆抗體
-
貨號:CSB-PA449091
-
規(guī)格:¥1100
-
圖片:
-
其他:
產(chǎn)品詳情
-
Uniprot No.:
-
基因名:
-
別名:grb 10 antibody; GRB IR antibody; grb-10 antibody; GRB10 adapter protein antibody; GRB10 adaptor protein antibody; GRB10 antibody; GRB10_HUMAN antibody; GRBIR antibody; Growth factor receptor bound protein 10 antibody; Growth factor receptor-bound protein 10 antibody; Insulin receptor binding protein antibody; Insulin receptor binding protein GRB IR antibody; Insulin receptor-binding protein Grb-IR antibody; IRBP antibody; KIAA0207 antibody; Maternally expressed gene 1 antibody; MEG1 antibody; RSS antibody
-
宿主:Rabbit
-
反應(yīng)種屬:Human
-
免疫原:Synthetic peptide of Human GRB10
-
免疫原種屬:Homo sapiens (Human)
-
標(biāo)記方式:Non-conjugated
-
抗體亞型:IgG
-
純化方式:Antigen affinity purification
-
濃度:It differs from different batches. Please contact us to confirm it.
-
保存緩沖液:-20°C, pH7.4 PBS, 0.05% NaN3, 40% Glycerol
-
產(chǎn)品提供形式:Liquid
-
應(yīng)用范圍:ELISA,IHC
-
推薦稀釋比:
Application Recommended Dilution ELISA 1:1000-1:10000 IHC 1:25-1:100 -
Protocols:
-
儲存條件:Upon receipt, store at -20°C or -80°C. Avoid repeated freeze.
-
貨期:Basically, we can dispatch the products out in 1-3 working days after receiving your orders. Delivery time maybe differs from different purchasing way or location, please kindly consult your local distributors for specific delivery time.
-
用途:For Research Use Only. Not for use in diagnostic or therapeutic procedures.
相關(guān)產(chǎn)品
靶點詳情
-
功能:Adapter protein which modulates coupling of a number of cell surface receptor kinases with specific signaling pathways. Binds to, and suppress signals from, activated receptors tyrosine kinases, including the insulin (INSR) and insulin-like growth factor (IGF1R) receptors. The inhibitory effect can be achieved by 2 mechanisms: interference with the signaling pathway and increased receptor degradation. Delays and reduces AKT1 phosphorylation in response to insulin stimulation. Blocks association between INSR and IRS1 and IRS2 and prevents insulin-stimulated IRS1 and IRS2 tyrosine phosphorylation. Recruits NEDD4 to IGF1R, leading to IGF1R ubiquitination, increased internalization and degradation by both the proteasomal and lysosomal pathways. May play a role in mediating insulin-stimulated ubiquitination of INSR, leading to proteasomal degradation. Negatively regulates Wnt signaling by interacting with LRP6 intracellular portion and interfering with the binding of AXIN1 to LRP6. Positive regulator of the KDR/VEGFR-2 signaling pathway. May inhibit NEDD4-mediated degradation of KDR/VEGFR-2.
-
基因功能參考文獻(xiàn):
- Through syngeneic comparison, our study identifies for the first time that Grb10 is associated with the pluripotency state in nuclear transfer embryonic stem cells. PMID: 28476045
- Data suggest that GRB10 and GRB14 are both Ca2+-dependent CaM-binding proteins; more than one CaM-binding site and/or accessory CaM-binding sites appear to exist in GRB10 and GRB14, as compared to a single one present in GRB7. (GRB10 = growth factor receptor-bound protein 10; GRB14 = growth factor receptor-bound protein 14; CaM = calmodulin; GRB7 = growth factor receptor-bound protein 7) PMID: 28295264
- GRB10 may regulate degradation of the IL-4 receptor-signaling complex through interactions with NEDD4.2. PMID: 27742835
- placental expression associated positively with placental weight, birth weight, and neonatal head circumference PMID: 26390806
- Risk alleles for 6 loci increased glucose levels from birth to 5 years of age (ADCY5, ADRA2A, CDKAL1, CDKN2A/B, GRB10, and TCF7L2 PMID: 27049325
- This study demonstrated that the most significant SNP (rs11770199; p = 0.0003) in single-site analysis was located on chromosome 7 in the GRB10 gene. PMID: 25391383
- Association of the intronic polymorphism rs12540874 A>G of the GRB10 gene with high birth weight. PMID: 25103788
- Tissue-specific methylation and possibly imprinting of GRB10 can influence glucose metabolism. PMID: 24699409
- Studies indicate that insulin receptor (IR) and IGF Type 1 Receptor (IGFR) have been identified as important partners of Grb10/14 and SH2B1/B2 adaptors. PMID: 23190452
- H19 and GRB10 methylation was normal in Albright's hereditary osteodystrophy patients. PMID: 22679513
- discovery of Grb10 as an mTORC1 substrate PMID: 21659604
- Grb10 interacts with Bim L and inhibits its proapoptotic activity in a phosphorylation-dependant manner. PMID: 20174874
- GRB10 gene is expressed from the paternal allele in the brain, but from the maternal allele in the placental trophoblasts. PMID: 19487367
- role in inhibiting insulin-stimulated insulin receptor substrate (IRS)-phosphatidylinositol 3-kinase/Akt signaling pathway by disrupting the association of IRS-1/IRS-2 with the insulin receptor PMID: 12493740
- The structure of this protein's SH domains affect ligand specificity. PMID: 12551896
- Grb10 acts as a positive regulator in VEGF-R2 signaling and protects VEGF-R2 from degradation by interacting with Nedd4, a component of the endocytic machinery PMID: 15060076
- GRB10 protein products are correlated with parameters of birth size. PMID: 15506681
- there is a phosphorylation-regulated complex formation of Grb10 with 14-3-3 and Akt PMID: 15722337
- Up-regulation of growth factor receptor-bound protein 10 is associated with cervical squamous cell carcinoma PMID: 15870923
- Ser(150) and Ser(476) of human Grb10zeta are phosphorylated in intact cells. PMID: 15952796
- Together, our results suggest that, in addition to inhibiting IR kinase activity by directly binding to the IR, Grb10 also negatively regulates insulin signaling by mediating insulin-stimulated degradation of the receptor. PMID: 16434550
- Single nucleotide polymorphism is associated with type 2 diabetes among Whites. PMID: 16644667
- GRB10 is a novel negative regulator of the Wnt signaling pathway. The finding that GRB10 interferes with the binding of Axin to LRP6 indicated a possible molecular mechanism by which the overexpression of GRB10 suppresses Wnt signaling. PMID: 17376403
- Binds to the Raf-1 and MEK1 kinases. Potential role in the regulation of apoptosis. PMID: 9553107
- Role in the regulation of mitogenesis by receptor tyrosine kinases. PMID: 10454568
- Mostly localized to the mitochondria. Can relocalize to the plasma membrane and lamellipodia under certain conditions. PMID: 10585452
顯示更多
收起更多
-
亞細(xì)胞定位:Cytoplasm.
-
蛋白家族:GRB7/10/14 family
-
組織特異性:Widely expressed in fetal and adult tissues, including fetal and postnatal liver, lung, kidney, skeletal muscle, heart, spleen, skin and brain.
-
數(shù)據(jù)庫鏈接:
Most popular with customers
-
-
YWHAB Recombinant Monoclonal Antibody
Applications: ELISA, WB, IHC, IF, FC
Species Reactivity: Human, Mouse, Rat
-
-
-
-
-
-